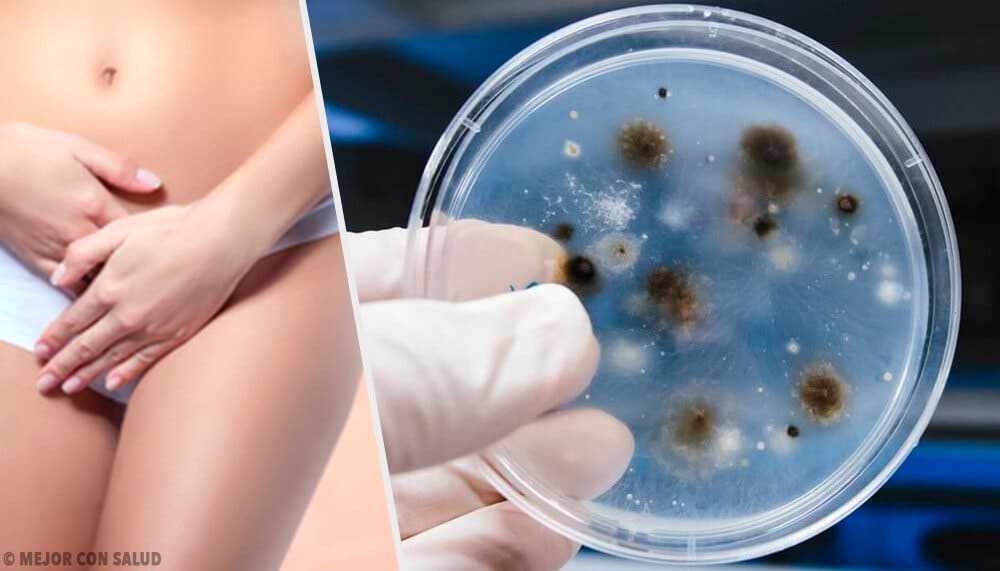

Infecciones vaginales: cómo evitarlas y cómo tratarlas


Revisado y aprobado por la médico Maricela Jiménez López
En la zona genital conviven de manera normal ciertos microorganismos que no perjudican al cuerpo, pero en ciertos casos el balance normal se ve alterado por lo que se producen las infecciones vaginales. ¿Quieres saber más al respecto? Entonces no dejes de leer todo lo que vamos a contarte a continuación.
Tal y como indican los expertos, por cuestión de anatomía, la mujer es muy propensa a sufrir varias infecciones vaginales a lo largo de su vida. Ahora bien, la buena noticia es que estas se pueden prevenir en muchos casos con la práctica de buenos hábitos de vida y las recomendaciones del ginecólogo.
¿Cuáles son las infecciones vaginales más comunes? ¿Por qué se producen?
Los desequilibrios en la microbiota o flora vaginal puede ser consecuencia de cambios hormonales, como los que experimenta la mujer durante el embarazo o la menopausia, pero también puede ser una consecuencia de la diabetes o el uso prolongado de antibióticos.
Las infecciones vaginales más comunes son la vulvovaginitis por hongos del género Candida, la vaginosis bacteriana por Gardnerella vaginalis y la tricomoniasis de transmisión sexual.
Descubre: Síntomas, tratamientos y prevención de la vulvovaginitis

¿Qué síntomas pueden causar?
Algunos de los síntomas más comunes que pueden causar las infecciones vaginales son los siguientes:
- Picazón de la zona.
- Dolor y ardor al orinar.
- Molestias durante el coito.
- Enrojecimiento de la vulva.
- Inflamación de los labios vaginales.
- Flujo vaginal abundante y con olor desagradable, entre otros.
Aunque consideres que los síntomas no son de gran intensidad, debes tener en cuenta que las infecciones vaginales deben ser tratadas de inmediato. En muchos casos las mujeres dejan de consultar con un médico por miedo o vergüenza, sin darse cuenta que una simple molestia puede convertirse en un problema mayor. Esto a su vez se traduce en un tratamiento y un periodo de recuperación más largo.
Remedios naturales y pautas de alimentación
En el ámbito popular se considera que se pueden complementar las indicaciones del médico con remedios naturales. En su mayoría, giran en torno a plantas a las que se le atribuyen propiedades antibacterianas, antiinflamatorias y antifúngicas. Las más destacadas serían las siguientes:
- Caléndula: se puede utilizar para prevenir infecciones vaginales. Posee propiedades antibióticas y antifúngicas. Colocar un poco de caléndula en agua hirviendo. Dejar enfriar y colocar en la zona afectada.
- Manzanilla: baños de asiento con su infusión.
Otras remedios naturales que se han recomendado en el ámbito popular son los siguientes:
- Aceite de árbol de té: colocar unas gotas en el agua de la bañera. Se ha visto que podría tener propiedades antimicrobianas.
- Yogur: el consumo de yogur natural es de gran ayuda para evitar las infecciones vaginales.
La alimentación también tiene un papel muy importante en estos casos, ya que cuanto más equilibrada esté, mayores beneficios podrá brindar.
Si tienes alguna duda sobre qué incluir y qué no en la alimentación, lo mejor será que consultes con un especialista en nutrición. Sin embargo, ten en cuenta que normalmente los expertos inciden en la importancia de la ingesta de los alimentos probióticos y los prebióticos.
Recomendaciones generales para superar las infecciones vaginales

Aunque lo mejor es consultar con el ginecólogo sobre el tema, a continuación te dejamos algunas recomendaciones que podrían ayudarte a lograr la mejoría:
- Mantener siempre una correcta higiene íntima.
- De ser posible con jabones de pH neutro que no alteran la flora normal de la vagina.
- No utilizar pantalones muy ajustados, ni ropa interior de material sintético. Recuerden que la zona íntima requiere de una correcta ventilación. En caso de aumentar la humedad de la zona los microorganismos se multiplican con mayor facilidad.
- Si utiliza protectores diarios cambiarlos al menos 4 veces al día, la misma recomendación en quienes utilizan tampones durante la menstruación.
- Lava tu ropa interior con jabón neutro.
- El uso de preservativo previene las infecciones de transmisión sexual.
- La vagina tiene un mecanismo de autolimpieza, solo se debe higienizar la parte externa.
- En el momento de ir al baño limpiarse de adelanta hacia atrás para evitar que bacterias que se encuentran normalmente en el ano lleguen a la vagina produciendo infecciones.
- Utilizar siempre ropa interior de algodón, ya que absorbe la humedad natural del cuerpo.
- Aunque parezca irónico no se debe abusar de la limpieza de la vagina, aún utilizando jabones aptos para la zona. Su uso es recomendado una vez al día, luego utilizar solo agua para la higiene.
- Llevar una vida más relajada, el estrés y la ansiedad bajan las defensas. Por lo que nos volvemos vulnerables a padecer enfermedades.
Las infecciones vaginales son comunes, pero es importante tratarlas para mantener una buena salud vaginal. No dudes en consultar con tu médico si crees que puedes tener algún síntoma.
En la zona genital conviven de manera normal ciertos microorganismos que no perjudican al cuerpo, pero en ciertos casos el balance normal se ve alterado por lo que se producen las infecciones vaginales. ¿Quieres saber más al respecto? Entonces no dejes de leer todo lo que vamos a contarte a continuación.
Tal y como indican los expertos, por cuestión de anatomía, la mujer es muy propensa a sufrir varias infecciones vaginales a lo largo de su vida. Ahora bien, la buena noticia es que estas se pueden prevenir en muchos casos con la práctica de buenos hábitos de vida y las recomendaciones del ginecólogo.
¿Cuáles son las infecciones vaginales más comunes? ¿Por qué se producen?
Los desequilibrios en la microbiota o flora vaginal puede ser consecuencia de cambios hormonales, como los que experimenta la mujer durante el embarazo o la menopausia, pero también puede ser una consecuencia de la diabetes o el uso prolongado de antibióticos.
Las infecciones vaginales más comunes son la vulvovaginitis por hongos del género Candida, la vaginosis bacteriana por Gardnerella vaginalis y la tricomoniasis de transmisión sexual.
Descubre: Síntomas, tratamientos y prevención de la vulvovaginitis
¿Qué síntomas pueden causar?
Algunos de los síntomas más comunes que pueden causar las infecciones vaginales son los siguientes:
- Picazón de la zona.
- Dolor y ardor al orinar.
- Molestias durante el coito.
- Enrojecimiento de la vulva.
- Inflamación de los labios vaginales.
- Flujo vaginal abundante y con olor desagradable, entre otros.
Aunque consideres que los síntomas no son de gran intensidad, debes tener en cuenta que las infecciones vaginales deben ser tratadas de inmediato. En muchos casos las mujeres dejan de consultar con un médico por miedo o vergüenza, sin darse cuenta que una simple molestia puede convertirse en un problema mayor. Esto a su vez se traduce en un tratamiento y un periodo de recuperación más largo.
Remedios naturales y pautas de alimentación
En el ámbito popular se considera que se pueden complementar las indicaciones del médico con remedios naturales. En su mayoría, giran en torno a plantas a las que se le atribuyen propiedades antibacterianas, antiinflamatorias y antifúngicas. Las más destacadas serían las siguientes:
- Caléndula: se puede utilizar para prevenir infecciones vaginales. Posee propiedades antibióticas y antifúngicas. Colocar un poco de caléndula en agua hirviendo. Dejar enfriar y colocar en la zona afectada.
- Manzanilla: baños de asiento con su infusión.
Otras remedios naturales que se han recomendado en el ámbito popular son los siguientes:
- Aceite de árbol de té: colocar unas gotas en el agua de la bañera. Se ha visto que podría tener propiedades antimicrobianas.
- Yogur: el consumo de yogur natural es de gran ayuda para evitar las infecciones vaginales.
La alimentación también tiene un papel muy importante en estos casos, ya que cuanto más equilibrada esté, mayores beneficios podrá brindar.
Si tienes alguna duda sobre qué incluir y qué no en la alimentación, lo mejor será que consultes con un especialista en nutrición. Sin embargo, ten en cuenta que normalmente los expertos inciden en la importancia de la ingesta de los alimentos probióticos y los prebióticos.
Recomendaciones generales para superar las infecciones vaginales

Aunque lo mejor es consultar con el ginecólogo sobre el tema, a continuación te dejamos algunas recomendaciones que podrían ayudarte a lograr la mejoría:
- Mantener siempre una correcta higiene íntima.
- De ser posible con jabones de pH neutro que no alteran la flora normal de la vagina.
- No utilizar pantalones muy ajustados, ni ropa interior de material sintético. Recuerden que la zona íntima requiere de una correcta ventilación. En caso de aumentar la humedad de la zona los microorganismos se multiplican con mayor facilidad.
- Si utiliza protectores diarios cambiarlos al menos 4 veces al día, la misma recomendación en quienes utilizan tampones durante la menstruación.
- Lava tu ropa interior con jabón neutro.
- El uso de preservativo previene las infecciones de transmisión sexual.
- La vagina tiene un mecanismo de autolimpieza, solo se debe higienizar la parte externa.
- En el momento de ir al baño limpiarse de adelanta hacia atrás para evitar que bacterias que se encuentran normalmente en el ano lleguen a la vagina produciendo infecciones.
- Utilizar siempre ropa interior de algodón, ya que absorbe la humedad natural del cuerpo.
- Aunque parezca irónico no se debe abusar de la limpieza de la vagina, aún utilizando jabones aptos para la zona. Su uso es recomendado una vez al día, luego utilizar solo agua para la higiene.
- Llevar una vida más relajada, el estrés y la ansiedad bajan las defensas. Por lo que nos volvemos vulnerables a padecer enfermedades.
Las infecciones vaginales son comunes, pero es importante tratarlas para mantener una buena salud vaginal. No dudes en consultar con tu médico si crees que puedes tener algún síntoma.
Este texto se ofrece únicamente con propósitos informativos y no reemplaza la consulta con un profesional. Ante dudas, consulta a tu especialista.









